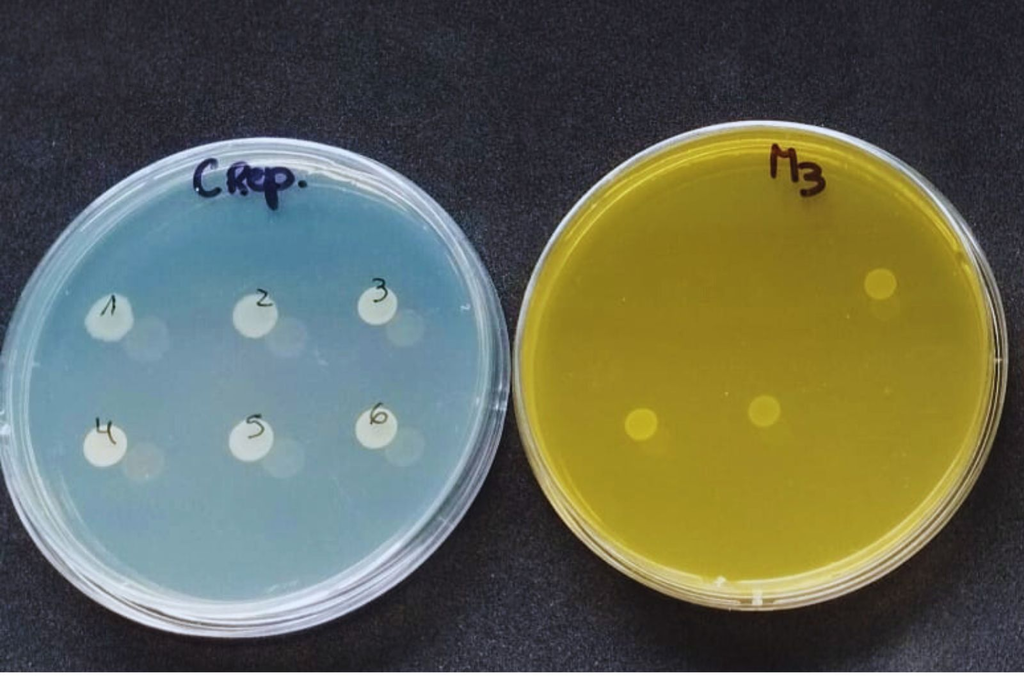

Un estudio conjunto del INTA, Conicet y la empresa Bedson verificó que los aceites esenciales de orégano y canela pueden mejorar la sanidad y el rendimiento animal sin generar resistencia bacteriana.
El avance de la resistencia a los antimicrobianos (RAM) es una de las principales preocupaciones globales, con impacto directo en la salud humana, la sanidad animal y el ambiente. Frente a este desafío, el sector agropecuario busca alternativas que permitan sostener la productividad sin comprometer la eficacia futura de los tratamientos.
En este marco, el Instituto de Patobiología Veterinaria (IPVet) del INTA-Conicet, en articulación con la empresa Bedson, evaluaron el potencial de aceites esenciales -particularmente los compuestos de orégano (carvacrol) y canela (cinamaldehído)- de inducir resistencia antimicrobiana, un riesgo clave a la hora de pensar en reemplazos de los antibióticos tradicionales.
Los ensayos, realizados en el Laboratorio de Bacteriología General del IPVet, determinaron que los compuestos analizados no generaron clones resistentes ni alteraron la sensibilidad de las bacterias a los antibióticos utilizados en salud animal.
“Los datos sugieren que, incluso tras una exposición prolongada, las bacterias no desarrollaron resistencia a los aceites esenciales”, explicó Johana Domínguez, investigadora del Conicet en el IPVet, quien detalló que los fitoquímicos presentes en estos aceites son compuestos naturales que, usados de forma continua en la alimentación animal, pueden mejorar el rendimiento productivo, la calidad de los productos y, lo más importante, garantizar su inocuidad.
Estos beneficios se deben a la capacidad de los aceites esenciales para modular la microbiota intestinal, estimular las defensas naturales del animal y mejorar la digestibilidad de los alimentos, actuando además como antioxidantes.
Además de este hallazgo, distintos estudios en pollos de engorde evidencian beneficios productivos y sanitarios sobre el uso de estos compuestos. “La inclusión de cinamaldehído (compuesto responsable del sabor y aroma característicos de la canela) y carvacrol (presente en el orégano) en la dieta de pollos de engorde mejora la ganancia de peso corporal y contribuye a mantener sistemas productivos sostenibles”, señaló Natalia Casanova, investigadora del IPVet del INTA e integrante del estudio.
Según expresó Casanova, “estos compuestos, junto con probióticos y bacteriófagos, conforman un conjunto de soluciones de bajo impacto ambiental que permiten mantener sistemas productivos sostenibles sin comprometer la eficacia terapéutica futura”.
Desde Bedson, empresa dedicada al desarrollo de aditivos alimenticios y productos farmacéuticos para uso veterinario, destacaron la importancia de contar con evidencia científica validada. “Junto al IPVet del INTA estudiamos si un aditivo tenía la potencialidad de inducir resistencia antimicrobiana. Los resultados confirmaron nuestras hipótesis y constituyen un hito que refuerza nuestra competitividad en un mercado internacional altamente exigente”, señaló Carlos Rodríguez, gerente de I+D de la compañía.
Se planteó un diseño experimental in vitro bajo una hipótesis que se había propuesto desde Bedson. En el laboratorio del INTA ya existía una metodología disponible para realizar los testeos, lo que permitió demostrar que la hipótesis de la empresa respecto del comportamiento de este producto era correcta.
Y agregó: “Con INTA hemos trabajado en líneas de investigación enfocadas en diversas especies animales y abordando varias necesidades del mercado. Estudiamos nuestras propias fórmulas, así como los principios activos que permiten desarrollar nuevos productos”.
El gerente aseguró que “en INTA encontramos profesionales muy idóneos y experimentados para llevar a cabo estas experiencias porque ya tenían los protocolos armados y estudiados y eso nos dio una ventaja enorme. Llevarlo a cabo con un Instituto reconocido es algo valorado por los clientes”.
Este caso es un ejemplo perfecto de como la articulación entre la ciencia y la industria privada generan innovaciones concretas que benefician al sector productivo, garantizan la salud animal y protegen la eficacia de los productos.
Fuente: INTA Informa.